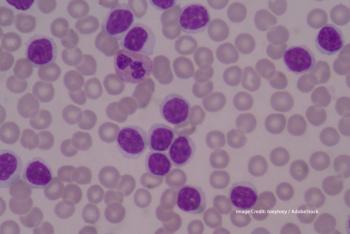

The authors explored the evidence supporting the safety and side effect profile of enasidenib, FDA-approved in August 2017 for relapsed/refractory AML.

Your AI-Trained Oncology Knowledge Connection!


The authors explored the evidence supporting the safety and side effect profile of enasidenib, FDA-approved in August 2017 for relapsed/refractory AML.

A recent study in JAMA Dermatology evaluated overall and leukemia-specific survival in patients with AML and leukemia cutis vs AML alone.

Researchers tested the addition of the T cell–boosting decitabine to anti–PD-1 therapy with camrelizumab among patients with relapsed or refractory classic Hodgkin lymphoma.

The MYD88 driver mutation was detected in the cerebrospinal fluid of a majority of patients with CNS lymphoma, indicating its potential utility as a diagnostic and monitoring tool.

Researchers looked at the treatment failure rate for immunotherapy with R-CHOP in patients with diffuse large B-cell lymphoma who were occupationally exposed to pesticides.

Researchers compared the newly developed PRIMA-PI risk score against FLIPI and FLIPI-2 in patients with follicular lymphoma.

Researchers are evaluating Iodine (131I) apamistamab plus HCT vs conventional care in older patients with active relapsed/refractory acute myeloid leukemia.

A new study evaluated combination venetoclax and low-dose cytarabine in previously untreated acute myeloid leukemia.

A retrospective study supported the role of primary radiotherapy in early-stage follicular lymphoma.

Researchers tested the PI3K inhibitor umbralisib in patients with relapsed/refractory marginal zone lymphoma in a phase II study that was presented at the AACR Annual Meeting.

Results of the phase III ADMIRAL trial, which tested the FLT3 inhibitor gilteritinib in patients with relapsed/refractory acute myeloid leukemia, were presented at the AACR Annual Meeting.

A recent study evaluated whether living in an industrial city could be an important risk factor for developing AML.

The PRECIS study looked at consolidation treatment with autologous stem cell transplantation vs whole-brain radiation therapy in younger patients with CNS lymphoma.

Although many immunotherapies for AML have been explored, none have ever been shown to reduced relapse rates.

The DYNAMO study investigated the oral PI3K gamma inhibitor duvelisib in heavily pretreated indolent non-Hodgkin lymphoma patients.

The combination of ibrutinib and nivolumab showed promising clinical response in patients with Richter’s Transformation.

Is Aurora A kinase inhibitor alisertib superior to standard treatment protocol for peripheral T-cell lymphoma?

Cancer Network speaks with Peter Ruvolo, PhD, about his work investigating the role of microenvironments in cancer and treatment resistance.

Investigators evaluated whether AZD3463 can induce apoptosis in a dose-dependent manner in a subset of AML patients.

The study, published in JAMA Oncology, examined whether treatment of 22 solid tumor types was associated with two therapy-related conditions.
Researchers evaluated the primary mechanisms governing drug resistance and relapse in patients treated with crenolanib, an FLT3 inhibitor.

A retrospective study finds that younger mantle cell lymphoma patients may achieve longer PFS with AHCT consolidation.

Allogeneic transplantation was found not to improve overall outcome, in particular for patients who achieved MRD-negative status after induction.

Dr. Daver discusses immunotherapy approaches for patients with acute myeloid leukemia (AML), and his recent study results on the combination of azacitidine and nivolumab.

Cancer Network sat down with Dr. Naval Daver to discuss advancements and discoveries in immunotherapy for AML patients.